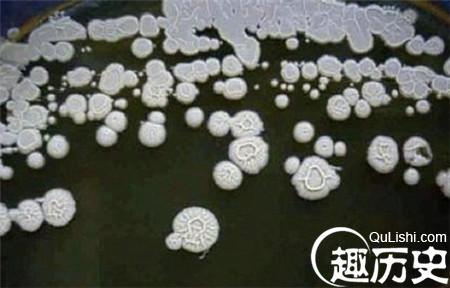

除了冬季的严寒,我们北边的好邻居又有一份礼物要带给我们。多亏了战斗民族,让上帝藏在他西伯利亚大冰箱里的又一件实验品得见天日。
网络配图
是的,这种藏在冻土里的细菌至今已经存在了350万年。2009年,国立莫斯科大学教授带队发现这种可以恢复细胞机能的细菌。先后在各种动植物实验上并展现惊人效果后,教授决定亲自体验这种逆天效果。
根据实验,注射了细菌的植物较对照组疯长,小白鼠也像打了鸡血一样战无不胜,大龄母鼠甚至恢复了生育能力。

网络配图
身兼发现者,实验者和实验品的教授现在自我感觉良好,不仅科研起来更持久,而且有两年多没有得过流感了。
被问及实验风险,教授说他一点也不担心自己。因为发现该菌的冻土正在融化,当地的河流应该受到了影响,当地人好像也变得更强壮了。

网络配图
细菌的作用机理并未查清,不过教授说并不影响人民加以利用,关键是效果(就像阿斯匹林)。
古代才子才是最风流的:四大女诗人被他抛弃了俩个
« 上一篇
盘点:中国历史上最著名的四大叛徒大揭晓
下一篇 »
